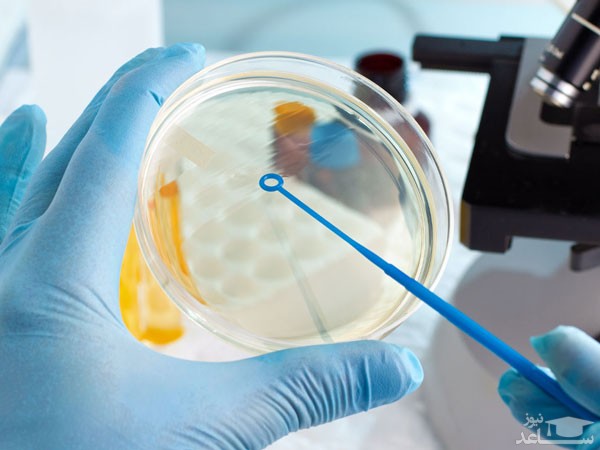
خرید محیط کشت

اگر دانشجوی یکی از رشته های علوم زیستی هستید یا قرار است به زودی در یک آزمایشگاه تحقیقاتی یا تشخیص پزشکی مشغول به کار شوید، یکی از تکنیک هایی که باید به آن مسلط باشید، روش آماده کردن انواع محیط کشت میکروبی و سلولی است. محیط های کشت سرشار از مواد غذایی مورد علاقه باکتری ها و سلول ها هستند و اگر کار با آنها را به درستی یاد نگرفته باشید، علاوه بر آلودگی محیط کشت و بی اعتبار شدن نتیجه آزمایش، ممکن است سلامتی خودتان هم به خطر بیفتد.
بنابراین لازم است قبل از ورود به آزمایشگاه و اتاق کشت، با نحوه آماده سازی انواع محیط کشت در محیط آزمایشگاه آشنا شوید و بایدها و نبایدهایی که ملزم به رعایت آنها هستید، بشناسید. در ادامه مطلب پیش رو، همه این موارد را به شما آموزش می دهیم. پس فرصت را از دست ندهید و با ما همراه باشید.

دستورالعمل آماده سازی، تهیه و کنترل کیفی محیط کشت
کشت سلولی و میکروبی مهم ترین روشی است که برای کشت دادن، بررسی و شمارش سلول های میکروبی و میکروارگانیسم های زنده در محیط آزمایشگاه استفاده می شود و محیط کشت در این فرایند نقش مهمی را ایفا می کند. برای اینکه بتوانیم از محیط کشت به شکل اصولی استفاده کنیم، باید مراحل زیر را به ترتیب طی کنیم:
-
خرید محیط کشت
اولین بخش از فرایند آماده سازی محیط کشت، خرید محیط کشت است. احتمالاً می دانید که محیط های کشت سلولی و میکروبی از نظر باکتریولوژی، حالت فیزیکی، مواد مغذی و ترکیبات داخلی با هم تفاوت دارند. بنابراین اولین موضوعی که در زمان خرید انواع محیط کشت باید به آن توجه کنید، ویژگی های محیط کشت و مناسب بودن آن برای آزمایش یا پروژه تحقیقاتی شماست. مثلاً اگر به محیطی با قدرت انتخابی بالا برای جداسازی گونه های باکتری سالمونلا نیاز دارید، باید محیط کشت میکروبی حاوی آگار تهیه کنید.
-
رعایت استانداردهای قبل از ورود به اتاق کشت
پس از تهیه محیط کشت مناسب، مرحله بعدی آماده شدن برای ورود به اتاق کشت است. اتاق کشت محیطی کاملاً ایزوله با تهویه مناسب است که استانداردهای لازم برای کشت انواع سلول های جانوری، گیاهی و کشت خرد زیستی در آن رعایت شده است. شما نیز به عنوان یک کارشناس، پیش از ورود به اتاق کشت باید چند اقدام مهم را انجام دهید:
- دست های خود را کامل بشویید، دستکش بپوشید و ماسک بزنید
- روپوش سفید و کاملاً تمیز بپوشید و کفش های خود را با کاور بپوشانید
- اگر بیمار هستید یا ممکن است در اثر عطسه یا سرفه باعث نشر آلودگی شوید، بهتر است وارد اتاق کشت نشوید.
-
داخل بخش اصلی اتاق کشت
بعد از رعایت نکات بهداشتی و ورود به اتاق کشت، درها را پشت سر خود ببندید تا آلودگی محیط بیرون با جریان هوا وارد اتاق کشت نشود. اطمینان حاصل کنید که سیستم تهویه اتاق به خوبی کار می کند. همچنین قبل از شروع به کار، روی میز و محل هایی که قرار است کار کنید، با الکل استریل کنید. سپس مواد و ابزارهای مورد نیاز خود را بردارید. برای این کار می توانید از لیست زیر کمک بگیرید:
- اسپری الکل 70 درصد
- محیط کشت (پودر یا ژل)
- سرم
- آنتی بیوتیک
- پتری دیش (پلیت)
- بن ماری
- هود لامینار
- اتوکلاو یخچال دار مخصوص کشت

-
طرز تهیه محیط کشت
برای شروع باید پلیت ها را به مدت 10 دقیقه داخل اتوکلاو قرار دهید تا کاملاً استریل شوند. سپس هود را روشن کنید و فضای داخل و خارج آن را با الکل ضدعفونی کنید. اگر محیط کشت آماده ندارید، باید خودتان آن را تهیه کنید. برای این کار باید سرم و آنتی بیوتیک را داخل بن ماری قرار دهید تا به دمای 37 درجه برسند. سپس داخل هر پلیت را با 10 درصد سرم و 0.1 درصد آنتی بیوتیک پر کنید.
حتماً هر ماده مغذی دیگری را که می خواهید به محیط کشت اضافه کنید به دمای 37 درجه برسانید تا به سلول ها شوک وارد نشود. البته با خرید محیط کشت میکروبی یا هر محیط کشت آماده دیگری، کارتان راحت تر می شود و دیگر نیازی به درست کردن محیط کشت نیست. فقط باید مطابق با دستورالعمل روی بسته بندی محیط کشت، مقدار معینی از آن را به همراه آب جوشانده شده داخل ارلن هم بزنید تا کاملاً شفاف شود و سپس آن را داخل پلیت بریزید.
-
کنترل کیفی محیط کشت
در خصوص نگهداری از محیط های کشت آماده شده باید به این موارد دقت کنید:
- برای اینکه از آلودگی محیط های آماده شده جلوگیری شود، باید آن ها را داخل اتوکلاو یخچال دار یا نهایتاً یخچال نگهداری کنید.
- هر روز یا حداکثر یک روز در میان به محیط کشت سر بزنید تا اگر نیاز به تعویض محیط یا اضافه کردن آنتی بیوتیک داشت، در بهترین زمان این کار را انجام دهید.
- حتماً مراقب باشید که در طبقه محیط کشت هیچ ماده دیگری نباشد که باعث نشر آلودگی یا ورود سایر مواد به داخل محیط کشت شود.
- هنگام کنترل محیط کشت حتماً دست ها، ابزارها و دستگاه ها را با الکل استریل کنید.
نکاتی کاربردی برای تهیه محیط کشت
در حین کار کردن با محیط کشت و آماده سازی آن احتمالاً با پرسش هایی مواجه خواهید شد که ممکن است روند کار شما را پیچیده کند. باید از قبل با این موضوعات آشنا باشید تا در صورت مواجه شدن با آنها، سریع ترین و بهترین راه حل ممکن را اجرا کنید!
-
تیره شدن محیط
علت مساله: حرارت دهی بیش از حد محلول محیط کشت و سوختن ترکیبات حاوی قند.
راه حل: تنظیم میزان حرارت و زمان حرارت دهی محیط های دارای گلوکز.
-
نبستن محیط کشت حاوی آگار
علت مساله: حل نشدن کامل آگار، تنظیم نبودن PH محیط، توزین نامناسب و افزودن محلول ها.
راه حل: از توزین دقیق پودر آگار، تنظیم بودن PH و حجم محلول های افزودنی به محیط مطمئن شوید.
-
رشد نامناسب یا عدم رشد
علت مساله: استفاده از مکمل و آنتی بیوتیک نامناسب، تلقیح باکتری ها در دمای بالا، تنظیم نبودن PH یا ترکیبات محیط.
راه حل: مکمل و آنتی بیوتیک را از شرکت های معتبر تهیه کنید. از حرارت دهی زیاد محلول پرهیز کنید. ساپلمنت های ضروری رشد سلول یا باکتری را کنترل کنید.
-
کدورت محیط کشت
علت مساله: حل نشدن کامل ترکیبات محیط کشت، حرارت دیدن بیش از اندازه، استفاده از آب نامناسب و توزین نامناسب.
راه حل: از آب مقطر با املاح و PH استاندارد استفاده کنید. از تمیز و استریل بودن شیشه آلات و تجهیزات آزمایشگاهی مورد استفاده، مطمئن شوید. اطمینان حاصل کنید که ترازو به درستی کار می کند.
شیمیبیو یکی از شرکت های معتبری است که در زمینه تأمین و فروش انواع محیط کشت سلولی و میکروبی فعالیت می کند. این شرکت نماینده رسمی فروش محصولات ایبرسکو ایران، لیوفیلکم ایتالیا و بایوآیدیا است. برای خرید محیط کشت سلولی از برترین برندهای داخلی و خارجی یا سفارش انواع محیط کشت میکروبی، فقط کافی است به نشانی shimibio.com مراجعه کنید. ضمانت کیفیت و اصالت کالا، ارسال سریع و قیمت مناسب از مهم ترین ویژگی های فروشگاه آنلاین شیمیبیو است.










































